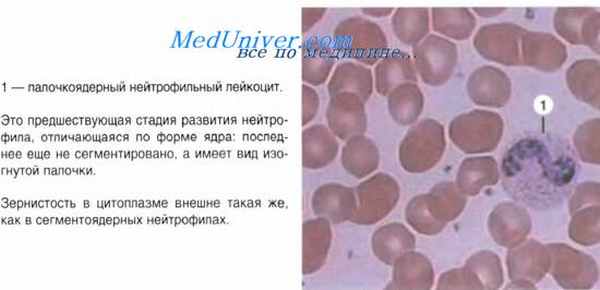
лейкоциты крови

Лейкоциты. Нейтрофилы. Эозинофильные гранулоциты.
Добавил пользователь Владимир З. Обновлено: 23.11.2025
Дарья КУСЕВИЧ, врач-ревматолог, заместитель главного врача Клиники доктора Аникиной, руководитель направления «Ревматология»
Общий уровень лейкоцитов выше 9х109/л называется лейкоцитозом. Физиологический лейкоцитоз наблюдается при мышечной работе, эмоциональном напряжении, боли, приеме белковой пищи, резкой смене температуры окружающей среды, ионизирующей радиации. Указанные причины должны исключаться или, если это невозможно, учитываться при интерпретации результатов исследования.
Реактивный лейкоцитоз считается результатом усиления лейкопоэза в ответ на выброс провоспалительных факторов (цитокинов, токсинов, продуктов активации комплемента) и наблюдается при острых инфекциях и воспалениях, интоксикациях, обширных повреждениях тканей, опухолях, острых анемиях, постспленэктомическом состоянии. Лейкоцитоз чаще наблюдается при остро развивающейся инфекции и значительно реже – при хронических заболеваниях. Однако при этом повышение лейкоцитов в крови редко сопровождается пропорциональными изменениями числа нейтрофилов, лимфоцитов, моноцитов, эозинофилов или базофилов. И как раз по соотношению в крови клеток разного вида (лейкоцитарная формула) врач может сделать предварительное заключение о причине лейкоцитоза и об эффективности проводимой терапии. Cнижение общего количества лейкоцитов (менее 4 000 в 1 мкл) называется лейкопенией, причем чаще всего она обусловлена нейтропенией. В ее основе могут лежать наследственные и врожденные аномалии, а также приобретенные иммунодефициты. Лейкопения может быть следствием перенесенных активных вирусных процессов, например гриппа. У пациентов с аутоиммунными заболеваниями допустим постоянный дефицит лейкоцитов, однако не менее 3 000 в 1 мкл. Однако, независимо от причины изменения лейкоцитарной формулы, клинически лейкопения проявляется в снижении фагоцитарной активности и подавлении специфических иммунологических механизмов защиты. Это, в свою очередь, обусловливает частые бактериальные и вирусные инфекции.
Лейкоцитоз чаще наблюдается при остро развивающейся инфекции, реже – при хронических заболеваниях. Однако при этом повышение лейкоцитов редко сопровождается пропорциональными изменениями числа нейтрофилов, лимфоцитов, моноцитов, эозинофилов или базофилов
Гранулоциты
Нейтрофилы составляют 50–70% всех лейкоцитов. Нейтрофилез, то есть концентрация нейтрофилов, превышающая 6х109/л, может наблюдаться как при реактивном лейкоцитозе (когда увеличивается абсолютное и процентное содержание нейтрофилов), так и при физиологическом лейкоцитозе. Любое воспаление, бактериальные, грибковые и паразитарные инфекции (локализованные и генерализованные), некротические изменения тканей, интоксикации, гипоксемия и опухоли различной локализации будут сопровождаться увеличением числа нейтрофилов.
Однако при длительном воздействии факторов, индуцирующих нейтрофилез, происходит истощение костномозгового гранулоцитарного резерва, и в кровь выходят молодые клетки нейтрофильного ряда: палочкоядерные нейтрофилы, метамиелоциты, миелоциты и промиелоциты (происходит так называемый сдвиг лейкоцитарной формулы влево). Такое состояние крови носит название лейкемоидной реакции нейтрофильного типа и требует проведения дифференциальной диагностики с хроническим миелолейкозом. В этом случае необходимы дополнительные исследования, в первую очередь – уровня щелочной фосфатазы нейтрофилов крови. При реактивных состояниях он будет высоким, при хроническом миелолейкозе – низким. Кроме того, о миелолейкозе говорит выявление мРНК химерного гена ВСR/АВL, а в трепанобиоптате – гиперплазии кроветворной ткани.
Лейкоцитоз чаще наблюдается при остро развивающейся инфекции, реже – при хронических заболеваниях. Однако при этом повышение лейкоцитов редко сопровождается пропорциональными изменениями числа нейтрофилов, лимфоцитов, моноцитов, эозинофилов или базофилов
При числе нейтрофилов ниже 1,5х109/л диагностируют нейтропению, причиной которой могут быть аутоиммунные заболевания (системная красная волчанка, аутоиммунный тиреоидит), метаболические расстройства, в частности дефицит витамина В12, фолиевой кислоты, меди, действие радиации. Нейтропения может развиваться на фоне длительного белкового голодания, в первом триместре беременности, на фоне приема лекарственных препаратов. При ряде заболеваний абсолютное число нейтрофилов может быть резко сниженным, в то время как число лейкоцитов крови остается нормальным или даже повышенным за счет, например, лимфоцитов и бластных клеток.
Нейтропения характерна и для острых, и для хронических вирусных инфекций (Эпштейна–Барр, цитомегаловирус, ВИЧ, парвовирус В19). Она возникает при передозировке лекарственных препаратов (иммунодепрессантов), тяжелых поражениях печени.
Отдельно выделяется агранулоцитоз – резкое снижение нейтрофильных гранулоцитов менее 0,5х109/л на фоне ионизирующей радиации, отравления химическими веществами (бензолом), инсектицидами. Причиной агранулоцитоза могут быть приобретенная аплазия кроветворения при апластической анемии и миелофиброзе, прием некоторых лекарственных препаратов, вызывающих угнетение кроветворения (цитостатиков, вальпроевой кислоты, карбамазепина, бета‑лактамных антибиотиков) либо действующих как гаптены (антитиреоидные препараты).
Риск развития агранулоцитоза высок у больных ревматоидным артритом (синдром Фетти) и с почечной недостаточностью, а также у пациентов, получающих системную иммуносупрессивную терапию. В свою очередь снижение нейтрофилов приводит к повышенной восприимчивости к бактериальным и грибковым инфекциям.
Эозинофилы составляют очень небольшую долю лейкоцитов – 0,5–5%. И их концентрация выше 0,4х109/л называется эозинофилией. Она чаще всего служит признаком аллергизации организма при атопическом дерматите, поллинозе, аллергическом рините, бронхиальной астме, сывороточной болезни. Количество эозинофилов растет прямо пропорционально содержанию циркулирующих кортикостероидов. Дифференцировка эозинофилов из лейкоцитов происходит под влиянием колониестимулирующего фактора роста и интерлейкинов‑3 и -5, причем самым мощным стимулом является интерлейкин‑5, который, кроме того, увеличивает продолжительность жизни эозинофилов.
Соответственно, повышение уровня эозинофилов может происходить и при ревматологических заболеваниях, чаще всего при синдроме Чарджа‑Стросса. При этом также увеличивается СОЭ, СРБ и IgE. Диагностическим критерием является скопление эозинофилов во внесосудистом пространстве. В биоптате обнаруживают некротический васкулит мелких артерий и вен.
Стойкая и значительная эозинофилия может быть вызвана глистными инвазиями, поскольку именно эозинофилы ответственны за уничтожение паразитов
Стойкая и значительная эозинофилия может быть вызвана глистными инвазиями, поскольку именно эозинофилы ответственны за уничтожение паразитов. Злокачественные новообразования также сопровождаются ростом эозинофилов за счет продукции опухолью веществ, стимулирующих их выработку. Эозинофилия характерна и для первичных иммунодефицитов, а также для хронических форм туберкулеза. А вот при острых вирусных и бактериальных инфекциях наблюдается обратная картина – эозинопения, т. е. снижение уровня эозинофилов в крови. Поэтому при лихорадящем состоянии выявление повышенного числа эозинофилов требует поиска неинфекционной причины повышения температуры.
Эозинофилия, продолжающаяся более 6 месяцев при отсутствии этиологического фактора, расценивается как гиперэозинофильный синдром, характеризующийся также тяжелыми органными нарушениями, обусловленными токсическим действием эозинофилов. В случае обнаружения клонального характера кроветворения может быть диагностирован хронический эозинофильный лейкоз.
Агранулоциты
Моноциты составляют 2–10% от общего числа лейкоцитов. Если их уровень в крови превышает 0,8х109/л, это состояние называется моноцитозом. Реактивный моноцитоз может развиваться при персистенции возбудителя или любого другого антигена в организме, т. е. при хронических длительных инфекциях, аутоиммунных заболеваниях, реактивных гистиоцитозах и опухолях. Однако здесь тоже есть нюанс. Моноцитоз возникает и при острых и хронических моноцитарных и миеломоноцитарных лейкозах. Поэтому диагноз «хронический лейкоз» может быть поставлен только после тщательного обследования пациента и исключения всех возможных причин, способных вызвать реактивный моноцитоз. Для лейкоза характерна выраженная гиперплазия кроветворного костного мозга с почти полным вытеснением жировой ткани в трепанобиоптате костного мозга, при цитогенетическом исследовании выявляется клональный гемопоэз.
Лимфоциты составляют весьма значительную долю лейкоцитов – 19–37%. Увеличение их уровня более 3х109/л, или лимфоцитоз, в основном обусловлено вирусными и хроническими бактериальными инфекциями.
Для лейкоза характерна выраженная гиперплазия кроветворного костного мозга с почти полным вытеснением жировой ткани в трепанобиоптате костного мозга, при цитогенетическом исследовании выявляется клональный гемопоэз
Из вирусных заболеваний стоит отметить инфекционный мононуклеоз, который сопровождается выраженной бласттрансформацией лимфоцитов и появлением этих клеток в крови, а также реактивным лимфаденитом. Диагностика в этом случае основывается на сочетании ведущих клинических симптомов (лихорадка, ангина, увеличение лимфоузлов и селезенки) с характерной гематологической картиной (лимфоцитоз, более 10% атипичных мононуклеаров в двух анализах с интервалом более 5 дней). Оценивая результаты анализа, следует учитывать возраст пациента и динамику количества атипичных мононуклеаров – они нарастают к 10‑му дню болезни, а затем медленно, на протяжении нескольких месяцев, снижаются.
В пользу этого диагноза свидетельствует выявление антител класса IgM к капсидным антигенам при первичной инфекции и к ядерным – при уже имеющейся. Во всех случаях инфекционного мононуклеоза обязательно обследование и на ВИЧ‑инфекцию, так как при последней нередки случаи мононуклеозоподобного синдрома: увеличение лимфоузлов и количества мононуклеаров в крови.
Наличие атипичных мононуклеаров характерно не только для инфекционного мононуклеоза. Их количество возрастает при любых вирусных инфекциях, вакцинациях, при аутоиммунных заболеваниях, лекарственной непереносимости.
Некоторые онкогематологические заболевания – лейкоз из больших гранулярных лейкоцитов и хронический лимфоцитарный лейкоз – также будут вызывать рост числа лимфоцитов. Диагноз «лейкоз» ставится только в случаях, когда другие причины лимфоцитоза отвергнуты. В неясных случаях следует выполнять иммунофенотипирование или тест на клональность. Диагностическая ценность этих методов намного выше, нежели гистологического или цитологического исследований. При хроническом лимфоцитарном лейкозе или лимфоме выявляется моноклональный клеточный лейкоцитоз >5 000 в 1 мкл крови, тогда как для реактивных состояний характерна поликлональность лимфоцитов.
В клиническом анализе крови в обязательном порядке определяют объем эритроцитов и концентрацию гемоглобина. По этим важным показателям можно судить о многих патологических процессах в организме. Более подробно об этом мы расскажем в нашей следующей статье.
Лейкоцитарная формула
Важно помнить! Информацию из данного раздела нельзя использовать для самодиагностики и самолечения. В случае боли или иного обострения заболевания диагностические исследования должен назначать только лечащий врач. Для постановки диагноза и правильного назначения лечения следует обращаться к Вашему лечащему врачу.
Другие названия: лейкограмма, формула крови, Leukocyte differential count, WBC differential.
Код услуги для заказа 4036 Мануальный подсчет лейкоцитарной формулы в медицинской лаборатории Синэво.
Общая информация
Лейкоциты (белые кровяные тельца) — это форменные элементы крови, основной функцией которых является защита организма от чужеродных агентов (токсинов, вирусов, бактерий, отмирающих клеток собственного организма и др.).
Лейкоцитарная формула – процентное соотношение различных видов лейкоцитов в сыворотке крови. Мануальный подсчет – это подсчёт клеток в окрашенном мазке крови под микроскопом. Лейкоциты делятся на 5 типов: нейтрофилы, лимфоциты, моноциты, эозинофилы, базофилы. Они отличаются по внешнему виду и выполняемым функциям.
Важно! Существует такое понятие, как сдвиг лейкоцитарной формулы влево и вправо. Сдвиг лейкоцитарной формулы влево – это когда в ответ на инфекцию сильно увеличивается продукция нейтрофилов, и в кровь выходят их незрелые палочкоядерные формы («палочки»). Сдвиг лейкоцитарной формулы вправо – увеличение количества зрелых сегментоядерных нейтрофилов с измененным строением ядер, что встречается при мегалобластных анемиях, заболеваниях печени и почек.
Показания к назначению исследования:
- плановое профилактическое обследование;
- обследование перед госпитализацией и оперативным вмешательством;
- диагностика инфекционных, воспалительных и гематологических заболеваний;
- мониторинг эффективности проводимой терапии или течения заболевания;
- аллергические реакции;
- опухоли.
Метод: ручной
Единицы измерения: %
Материал для исследования: венозная (капиллярная) кровь
Рекомендации по подготовке к анализу:
Интерпретация результатов:
Результат лабораторных исследований не является достаточным основанием для постановки диагноза. Интерпретация результатов и постановка диагноза осуществляется только лечащим врачом.
Нейтрофилы (NEUT), Neutrophils
Нейтрофилы — наиболее многочисленная разновидность лейкоцитов, составляют 50-75% от общего количества белых клеток. При развитии инфекционного или воспалительного процесса внутри нейтрофилов активируются особые вещества, необходимые для разрушения возбудителя или собственных пораженных клеток. Нейтрофилы активно движутся к месту инфекции и выполняют свою защитную функцию.
Выделяют сегментоядерные (зрелые) нейтрофилы и небольшое количество (1-5% от общего количества) палочкоядерных (более молодых) нейтрофилов.
Расшифровка у детей и взрослых
Референтные значения (норма)
Дети
2 недели-1 год: 16-45;
Взрослые: 40-72.
Возможные причины повышения уровня нейтрофилов:
- острые локализованные бактериальные инфекции (абсцессы, остеомиелит, острый аппендицит, отит, пневмония, острый пиелонефрит, сальпингит, менингиты (гнойные и туберкулёзный, др.), ангина, острый холецистит, тромбофлебит и др.);
- острые генерализованные бактериальные инфекции (сепсис, перитонит, эмпиема плевры, скарлатина, холера и др.);
- воспаление или некроз ткани: инфаркт миокарда, обширные ожоги, гангрена, быстро развивающаяся злокачественная опухоль с распадом, узелковый полиартериит, острая ревматическая лихорадка;
- интоксикации экзогенные: свинец, змеиный яд, вакцины, бактериальные токсины;
- интоксикации эндогенные: уремия, диабетический ацидоз, подагра, эклампсия, синдром Кушинга;
- миелопролиферативные заболевания (хронический миелолейкоз, эритремия);
- острые геморрагии.
Возможные причины понижения уровня нейтрофилов:
- бактериальные инфекции (тиф, паратиф, туляремия, бруцеллёз, подострый бактериальный эндокардит);
- вирусные инфекции (инфекционный гепатит, грипп, корь, краснуха);
- миелотоксические влияния и супрессия гранулоцитопоэза:
- ионизирующее излучение;
- химические агенты (бензол, анилин и др.);
- дефицит витамина В12 и фолиевой кислоты;
- острый лейкоз;
- апластическая анемия;
- иммунный агранулоцитоз:
- гаптеновый (гиперчувствительность к медикаментам);
- аутоиммунный (СКВ, РА, хронический лимфолейкоз);
- изоиммунный (у новорождённых, посттрансфузионный);
- перераспределение и секвестрация нейтрофилов в органах:
- анафилактический шок;
- спленомегалия различного происхождения;
- наследственные формы нейтропении (циклическая нейтропения, семейная доброкачественная нейтропения и др.).
Вещества и препараты, влияющие на повышение уровня нейтрофилов: стероиды, препараты дигиталиса
Вещества и препараты, влияющие на понижение уровня нейтрофилов: пенициллин, антитиреоидные препараты, карбамазепин, вальпроевая кислота, мышьяк, ртуть, индометацин, ибупрофен, ацетилсалициловая кислота, барбитураты, диазепам, галоперидол, каптоприл, пропранолол, гидралазин, метилдопа, диазоксид, нифедипин, нитрофурантоин, гризеофульвин, метронидазол, рифампицин, изониазид, стрептомицин, сульфаниламиды, имипенем, противомалярийные препараты, противовирусные препараты, антидиабетические препараты, диуретики, противоопухолевые препараты (цитостатики, иммуносупрессанты).
Лимфоциты (LYMPH), lymphocytes
Лимфоциты — это важнейшие клеточные элементы иммунной системы. Они выполняют различные функции: распознают возбудителей болезни, изменения и уничтожения клеток собственного организма, а также дают гуморальный ответ в виде синтеза антител – специальных защитных белков. Лимфоциты участвуют в формировании иммунологической памяти – способности организма к ускоренному и усиленному иммунному ответу при повторной встрече с чужеродным агентом.
Референтные значения (норма)
Дети
0-2 недели: 22-55;
2 недели-1 год: 25-70;
1-2 года: 30-65;
2-5 лет: 30-60;
6-7 лет: 30-50;
9-11лет: 30-46;
12-15 лет: 20-50;
16-18 лет: 20-50.
Взрослые: 20-40.
Возможные причины повышения уровня лимфоцитов:
- вирусные инфекции (инфекционный мононуклеоз, цитомегаловирус, краснуха, ветряная оспа);
- токсоплазмоз;
- некоторые бактериальные инфекции (туберкулёз, коклюш);
- онкологические заболевания костного мозга (хронический лимфолейкоз) и лимфоузлов (неходжкинская лимфома);
- острый вирусный гепатит;
- макроглобулинемия Вальденстрема;
- травматические повреждения тканей;
- злокачественные опухоли (особенно карцинома бронхов);
- уремия;
- эклампсия;
- заболевания щитовидной железы;
- острое кровотечение;
- постспленэктомия.
Возможные причины понижения уровня лимфоцитов:
- тяжёлые вирусные заболевания (грипп);
- острые бактериальные инфекции;
- системная красная волчанка;
- некоторые врожденные заболевания новорождённых (синдром Ди Джорджа);
- гиперспленомегалия;
- интоксикация тяжелыми металлами, при ионизирующем излучении;
- заболевания костного мозга — первичные и вторичные (гранулемы, метастазы);
- мегалобластная, апластическая анемия;
- миелодиспластические синдромы;
- наследственные заболевания (анемия Фанкони, наследственный дискератоз);
- почечная недостаточность;
- недостаточность кровообращения;
- вторичный иммунодефицит;
- ВИЧ/СПИД;
- злокачественные новообразования.
Вещества и препараты, влияющие на повышение уровня лимфоцитов:
аминосалициловая кислота, цефтазидим, дексаметазон, галоперидол, леводопа, офлоксацин, тиоурацил, спиронолактон, вальпроевая кислота.
Вещества и препараты, влияющие на понижение уровня лимфоцитов: аспарагиназа, бензодиазепины, цефтриаксон, циклоспорин, фолиевая кислота, фуросемид, ибупрофен, левофлоксацин, литий, офлоксацин, глюкокортикоиды.
Моноциты (MONO), Monocytes.
Моноциты — это самые крупные клетки, циркулирующие в крови, мигрируя в очаг воспаления они поглощают микробы, погибшие лейкоциты, а также поврежденные клетки воспаленной ткани, очищая этим очаг воспаления и подготавливая его для восстановления. За эту функцию моноциты называют «дворниками организма». Также моноциты синтезируют большое количество биологически активных веществ, необходимых для жизненно важных процессов в организме.
Референтные значения
Дети
2 недели-1 год: 5-20;
1года -18 лет: 2-10.
Взрослые: 2-10.
Возможные причины повышения уровня моноцитов:
- подострый бактериальный эндокардит, период выздоровления после острых инфекций, вирусные (мононуклеоз), грибковые, риккетсиозы и протозойные инфекции (малярия, лейшманиоз);
- туберкулёз, особенно активный, сифилис, бруцеллёз, саркоидоз, язвенный колит;
- острый монобластный и миеломоноцитарный лейкозы, хронический моноцитарный, миеломоноцитарный и миелолейкоз, лимфогранулематоз;
- системная красная волчанка, ревматоидный артрит, узелковый полиартериит.
Вещества и препараты, влияющие на повышение уровня моноцитов: ампициллин, гриеофульвин, галоперидол, пеницилламин, преднизолон.
Эозинофилы, эозинофильные гранулоциты (ЕОS), Eosinophils
Это клетки, которые захватывают чужеродный материал, слишком крупный для нейтрофилов. Эозинофилы присутствуют в очагах воспаления, вызванных аллергическими заболеваниями, например, при бронхиальной астме. Высвобождение биологически активных веществ из эозинофила — составная часть механизма развития аллергических реакций. Так же их выработка увеличивается при заражении гельминтами.
Референтные значения (норма)
Дети
Взрослые: 0-6.
Возможные причины повышения уровня эозинофилов:
- аллергические заболевания (бронхиальная астма, сенная лихорадка, аллергический дерматит, лекарственная аллергия);
- инвазии паразитов (аскаридоз, токсокароз, трихинеллез, эхинококкоз, шистосомоз, филяриоз, стронгилоидоз, описторхоз, лямблиоз, анкилостомидоз);
- гемобластозы (острый лейкоз, хронический миелолейкоз, эритремия, лимфомы, лимфогранулематоз), другие опухоли, особенно с метастазами или некрозом;
- иммунодефициты (синдром Вискотта-Олдрича);
- болезни соединительной ткани (узелковый полиартериит, ревматоидный артрит);
- эозинофильный эзофагит, эозинофильный гастроэнтерит, эозинофильный колит (связан с аллергией на коровье молоко, хотя может возникнуть у детей, которых кормили соевыми детскими смесями или грудью);
- инфекционные заболевания на стадии выздоровления при других инфекциях;
- наследственная эозинофилия;
- неаллергический эозинофильный ринит.
Возможные причины понижения уровня эозинофилов:
- начальная фаза инфекционно-токсического процесса;
- тяжёлое состояние у пациентов в послеоперационном периоде.
Вещества и препараты, влияющие на повышение уровня эозинофилов: аллопуринол, аминосалициловая кислота, амоксициллин, амфотерицин В, ампициллин, каптоприл, цефотаксим, цефтазидим, цефтриаксон, доксициклин, эналаприл, гентамицин, галоперидол, вакцина от гепатита А, офлоксацин, пеницилламин, ранитидин, рифампицин, спиронолактон, стрептомицин.
Вещества и препараты, влияющие на понижение уровня эозинофилов: амитриптилин, аспирин, каптоприл, кортикотропин, индометацин, рифампицин, сульфаметоксазол.
Базофилы (базофильные гранулоциты, «тучные клетки», BASO), Basophils
Главная функция базофилов — участие в аллергических реакциях немедленного типа. Основной компонент этих клеток – белок гистамин, который запускает аллергические процессы.
Референтные значения (норма)
у взрослых и детей: 0-1,0
Возможные причины повышения уровня базофилов:
- аллергические заболевания (аллергический ринит, назальные полипы, хронический синусит, бронхиальная астма, атопический дерматит, лекарственная аллергия);
- мегакариобластная лейкемия при синдроме Дауна (трисомия 21);
- хронический миелолейкоз и другие хронические миелопролиферативные синдромы (истинная полицитемия, миелоидная метаплазия с миелофиброзом);
- системный мастоцитоз, пигментная крапивница (педиатрическая форма ограниченной мастоцитарной пролиферации, с кожной локализацией);
- базофильная лейкемия;
- болезнь Ходжкина;
- хроническая гемолитическая анемия, постспленэктомия;
- последствия ионизирующего облучения;
- инфекции различной этиологии (туберкулез, ветряная оспа, грипп);
- гипотиреоз.
Возможные причины понижения уровня базофилов:
- острая фаза инфекционных заболеваний;
- реакция на стресс (беременность, инфаркт миокарда);
- результат длительного лечения стероидами, химиотерапии, облучения;
- врожденное отсутствие базофилов;
- острая ревматическая лихорадка у детей;
- гипертиреоз;
- крапивница;
- бронхиальная астма;
- анафилактический шок;
- системный мастоцитоз, пигментная крапивница, мастоцитарная лейкемия;
- макроглобулинемия, лимфомы с медуллярной инвазией;
- кортикосупраренальная недостаточность;
- хронические заболевания печени и почек;
- остеопороз.
Дополнительные субпопуляции клеток
Атипичные мононуклеары – клетки лимфоидной природы, возникающие в ответ на вирусные инфекции, чаще всего на инфицирование вирусом Эпштейна-Барр (инфекционный мононуклеоз), но могут обнаруживаться и при других вирусных заболеваниях.
Плазматические клетки – антителообразующие клетки лимфоидной природы. Обычно находятся в лимфатических узлах и селезенке. Могут появляться в кровотоке при инфекционных заболеваниях. Присутствие 1-2% плазматических клеток можно считать вариантом нормы. Присутствие большого количества плазматических клеток (более 10%) характерно для ряда онкогематологических заболеваний.
Палочкоядерные нейтрофилы – «молодые» нейтрофилы с несегментированным ядром. В норме их количество составляет 1-6% от общего количества лейкоцитов. Повышенное содержание палочкоядерных нейтрофилов обычно свидетельствует о наличии инфекционного или воспалительного процесса.
Юные миелоциты – незрелые клетки гранулоцитарного ряда, предшественники палочкоядерных нейтрофилов. Их присутствие также может свидетельствовать о наличии инфекционного или воспалительного процесса. Могут появляться при приеме некоторых лекарственных препаратов. В небольшом количестве в норме могут присутствовать у беременных женщин и новорожденных детей.
Миелобласты, промиелоциты и миелоциты — клетки-предшественники взрослых нейтрофилов. Могут появляться в мазке крови в исключительных случаях, например, при тяжелых инфекционных заболеваниях, а также при хроническом миелолейкозе (злокачественном заболевании кроветворной системы).
Где сдать мануальный подсчет лейкоцитарной формулы
Сдать анализ крови на мануальный подсчет лейкоцитарной формулы можно в любом пункте Синэво в Минске, Барановичах, Бобруйске, Борисове, Бресте, Витебске, Ганцевичах, Гомеле, Гродно, Жлобине, Лиде, Могилеве, Мозыре, Молодечно, Новогрудке, Новополоцке, Орше, Пинске, Полоцке, Речице, Светлогорске, Слуцке, Сморгони, Солигорске.
Подробную информацию по ценам и срокам выполнения анализов Вы можете получить в разделе "Анализы" или по телефонам:
7766 звонок бесплатный для абонентов МТС и life:) звонок платный для абонентов A1 (по тарифам оператора) +375 (17) 338 88 88 звонок платный, тарифицируется как исходящий вызов на фиксированную сеть
Режим работы колл-центра понедельник-пятница: с 07:00 до 19:00 суббота: с 07:00 до 16:00 воскресенье: с 8:00 до 16:00
Лейкоциты. Нейтрофилы. Эозинофильные гранулоциты.
Лейкоциты. Нейтрофилы. Эозинофильные гранулоциты.
Лейкоцитами называют белые клетки крови. Число их в 1 л крови во много раз меньше, чем эритроцитов и составляет 4-9х109. Они подразделяются на две группы: зернистые лейкоциты (гранулоциты) и незернистые лейкоциты (агранулоциты). Для зернистых лейкоцитов характерны следующие основные особенности: наличие в цитоплазме специфической зернистости и сегментация ядра. По окраске зернистости гранулоциты подразделяются на 3 вида: нейтрофильные, эозинофильные, базофильные. Основная функция гранулоцитов — участие в защитных реакциях организма в соединительных тканях. Схематично жизненный путь гранулоцитов можно представить в виде трех этапов: развитие в костном мозге, кратковременная циркуляция в кровеносном русле, пребывание в тканях. Главное назначение гранулоцитов — попасть в ткани, где они и выполняют свои функции.
Наличие в нейтрофильных гранулоцитах гидролитических и окислительных ферментов связано с фагоцитарной активностью этих клеток (около 80% клеток обладают этим свойством). И. И. Мечников называл нейтрофилы микрофагами. Так, одна клетка может поглотить в среднем до 9 кишечных палочек.
Увеличение количества нейтрофилов при мышечной работе, заболеваниях и экстремальных состояниях организма называют лейкоцитозом. При этом возрастает доля малодифференцированных — палочкоядерных и юных форм, что называется сдвигом влево.
Эозинофильные гранулоциты (эозинофилы) — округлые клетки диаметром 10-12 мкм. Они встречаются в периферической крови реже, чем нейтрофилы, составляя 1-5% от общего числа лейкоцитов. Ядро эозинофилов имеет, как правило, двухсегментную конфигурацию. Характерным признаком эозинофильных лейкоцитов является крупная эозинофильная зернистость, равномерно расположенная в цитоплазме. Гранулы имеют округлую или овальную форму, окрашиваются эозином в ярко-красный цвет. Мелкие азурофильные (неспецифические, первичные) гранулы (около 5%) диаметром до 0,4 мкм содержат кислую фосфатазу, пероксидазу и другие ферменты — это лизосомы. Крупные эозинофильные гранулы — это специфические (вторичные), размером до 1,5 мкм и числом около 200 содержат кристаллоид. В нем находится главный щелочной (основной) белок и другие ферменты, которые участвуют в антипаразитарной функции клеток. При контакте с паразитом эозинофилы секретируют содержимое гранул, в частности главный щелочной белок, который разрушает оболочку паразита.
Количество эозинофилов значительно увеличивается (до 20-40%) при аллергических состояниях (например, при бронхиальной астме). Так, при аллергических состояних и воспалении эозинофильные лейкоциты активно перемещаются к источнику раздражения, например, к гистамину, выделяемому тучными клетками, поглощают и разрушают его, уменьшая степень выраженности местных реакций в тканях. Кроме того, эозинофилы связывают комплексы антиген-антитело.
Фагоцитарная активность клеток ниже, чем у нейтрофилов. Длительность пребывания клеток в крови составляет 3-10 часов. Затем они мигрируют в ткани и находятся там до 2 недель. Удаление стареющих эозинофилов происходит через эпителий кишечной трубки. При проникновении паразитов в пищеварительную трубку миграция эозинофилов возрастает, как и увеличивается продукция этих клеток в костном мозге, что сопровождается эозинофилией.
- Вернуться в оглавление раздела "гистология"
Информация на сайте подлежит консультации лечащим врачом и не заменяет очной консультации с ним.
См. подробнее в пользовательском соглашении.
Лейкоциты. Нейтрофилы. Эозинофильные гранулоциты.
8.1. Введение
8.1.1 Ткани внутренней среды
кровь и лимфа ,
собственно соединительные ткани ,
соединительные ткани со специальными свойствами (ретикулярная, жировая, слизистая),
скелетные соединительные ткани - хрящев ые и костн ые .
а) разнообразие клеток почти в каждой из них,
б) хорошо развитое межклеточное вещество, находящееся в
жидком ( кровь, лимфа ),
гелеобразном (собственно соединительн ые ткан и ) или
твёрдом (скелетные соединительные ткани) состоянии;
в) происхождение из мезенхимы.
Д анная тема посвящена крови.
8.1.2 Состав крови
плазму (межклеточное вещество) - 55- 60 % объёма крови (около 3 л ) и
форменные элементы - 40-45 % объёма крови.
плазма - светло-жёлтая надосадочная жидкость.
воду ( примерно 90 % от массы),
белки (6,5 - 8,5 %) - альбумины, глобулины и фибриноген ,
многочисленные низкомолекулярные органические соединения -
промежуточные или конечные продукты обмена веществ, переносимые из одних органов в другие ;
различные неорганические ионы -
в свободном состоянии или
в связи со специальными транспортными белками.
эритроциты (красные кровяные тельца) - 5 · 10 12 1/л,
лейкоциты (белые кровяные клетки) - 6 · 10 9 1/л,
тромбоциты (кровяные пластинки) - 2,5 · 10 11 1/л.
б) Как видно, по сравнению с эритроцитами,
лейкоцитов меньше примерно в 1000 раз,
а тромбоцитов - в 20 раз.
поступление в кровь новых порций данного компонента и
удаление из крови примерно таких же его количеств.
б) Так, средняя продолжительность циркуляции эритроцитов -
непрерывно циркулируют в крови всего 4 - 12 часов ,
многократно выходят из крови в разные ткани и вновь возвращаются в кровь,
и общая продолжительность их жизни составляет (в зависимости от вида лейкоцита) от нескольких недель до нескольких месяцев.
8.2. Эритроциты
8.2.1. Морфология и состав
8.2.1.1. Цитологическая характеристика
ядра,
митохондрий,
эндоплазматического ретикулума с рибосомами и
ряда других органелл.
б) Чаще всего (в 85 %) они имеют форму двояковогнутых дисков диаметром 7,5 мкм.
ретикулоциты (2 - 8 % от общего числа эритроцитов).
тоже лишены ядер,
но содержат зернисто-сетчатые структуры - стареющие митохондрии, остатки эндоплазматической сети и рибосом.
в) А. При обычной окраске (по Романовскому, т.е. азур II-эозином) ретикулоциты неотличимы от эритроцитов.
Б. Наличие зернисто-сетчатых структур выявляется при специальной окраске - крезиловой синькой.
а) При т.н. кренировании
образуются выпячивания плазмолеммы (в виде шипов ),
а форма клетки приближается к эллипсоидной и затем сферической.
- Дискоциты превращаются в
эхиноциты (эллипсоидные клетки с "шипами"; 6% от всех эритроцитов) и затем в
сфероциты (сфероидные клетки без шипов; 1%) .
б) Во втором случае
двояковогнутая форма клетки меняется на вогнуто-выпуклую или куполообразную.
8.2.1.2. Молекулярный состав
I. Индивидуальные белки плазмолеммы
В мембране эритроцитов идентифицировано несколько десятков различных белков.
Ниже указываются самые известные из них.
имеет палочкообразную форму и,
стыкуясь друг с другом "конец в конец", образует на внутренней поверхности плазмолеммы сетку .
б) Последняя придаёт мембране
эластичность и упругость .
б) С внешней стороны мембраны с его пептидной цепью связаны олигосахаридные остатки, в т.ч.
остатки сиаловой кислоты.
в) Последние содержат ионизированные карбоксильные группы, которые придают эритроциту
существенный отрицательный заряд.
II. Групповые антигены плазмолеммы
обладают выраженными антигенными свойствами ,
которые у разных людей могут различаться.
б) Исходя из структуры одного из этих антигенов, людей (равно как и кровь) делят на 4 группы ( система АВО ):
0 (I), А (II), B (III), АВ (IV).
в) По структуре ещё одного антигена ( резус-фактора ) людей делят на
резус-отрицательных и резус-положительных.
а) У людей группы крови I
эритроциты имеют на поверхности антиген 0 (ноль),
а в плазме крови циркулируют антитела антиА и антиВ.
б) У людей же группы крови II
эритроциты имеют на поверхности, кроме антигена 0, также антиген А,
а в плазме крови циркулирует антитело антиВ.
б) В частности, это происходит при переливании крови группы II людям группы III (или наоборот). Тогда
антитела реципиента вызывают агглютинацию (слипание) эритроцитов донора .
во многих секретах (включая слюну, молоко, семенную жидкость) и
на поверхности тромбоцитов и ряда клеток в разных тканях.
III. Важнейшие белки цитоплазмы
б) Это белок, участвующий в газообмене -
переносе кислорода от лёгких к тканям
и СО 2 от тканей к лёгким .
8.2.2.1. Строение
две a - и
две b -субъединицы.
Таким образом, Hb является тетрамерным белком.
сам атом Fe закреплён в геме,
гем связан с белковой субъединицей,
молекула О 2 или СО 2 связывается с Hb.
в молекуле Hb - 4 атома Fe (II),
и через них с молекулой Hb может связаться до 4-х молекул О2.
отдельным эр итроцитам в свежей крови - жёлтый цвет,
а самой крови (в силу большого содержания эритроцитов) - красный цвет .
б) После разрушения (в селезёнке) эритроцитов и самого Hb
атомы Fe в большинстве своём вновь используются для нужд организма (в т.ч. для синтеза Hb),
а остальная часть гема превращается в желчные пигменты (билирубин и биливердин), которые обусловливают обычный цвет мочи и кала.
8.2.2.2. Виды Hb
Hb эмбрионов,
Hb F - фетальный гемоглобин,
Hb A - гемоглобин взрослых и
Hb A 2 .
б) В частности, у Hb F данное сродство выше, чем у Hb А;
благодаря этому, кислород диффундирует
от Hb A (циркулирующего в материнской крови)
к Hb F (циркулирующему в крови плода).
Hb A (96 % от всего Hb),
Hb A 2 и
Hb F (примерно по 2 %).
а) На препаратах основная часть форменных элементов крови представлена эритроцитами (которых, как отмечалось, в 1000 раз больше, чем лейкоцитов).
Эритроциты отличаются характерной морфологией:
имеют на препарате округлую форму и относительно постоянный диаметр ,
э озином окрашиваются в розовый цвет ,
в центре - более светлые, что объясняется формой клеток - в виде двояковогнутого диска.
8.3. Лейкоциты
имеют шаровидную форму,
содержат ядро,
а по размеру - крупнее эритроцитов.
8.3.1.1 Классификация (лейкоцитарная формула)
1. В следующей таблице
приведена морфологическая классификация лейкоцитов
и указано среднее относительное содержание каждого их вида (от общего числа лейкоцитов).
2. Совокупность этих значений называется лейкоцитарной формулой крови .
Бактериальная инфекция по анализу крови

Общий анализ крови (ОАК) - это лабораторный метод, позволяющий объективно оценить качественный и количественный состав клеток крови для диагностики различных заболеваний. Подсчет количества лейкоцитов (WBC), процентное соотношение лейкоцитов (лейкоцитарная формула) и СОЭ (скорость оседания эритроцитов) - основные параметры, отражающие активность вирусных и бактериальных инфекций.
Лейкоциты WBC – «белые рыцари» иммунной системы. Лейкопоэз (образование лейкоцитов) происходит в красном костном мозге. В зависимости от морфологических особенностей (размер клетки, форма ядра, наличие специфических гранул) и функции, которую они выполняют, лейкоциты разделяют на две группы: гранулоциты (нейтрофильные, базофильные и эозинофильные лейкоциты), агранулоциты (моноциты, лимфоциты).
· Нейтрофилы (NE) В сосудистом русле в норме циркулируют два типа NE: палочкоядерные (молодые) и сегментоядерные (зрелые). Более юные элементы гранулоцитарного ряда выходят в кровь из красного костного мозга только при патологии. Основная функция NE- уничтожение микроорганизмов, путем распознавания, активного захвата, и переваривания микробного агента (фагоцитоз). Нейтрофилы участвуют во всех этапах воспалительного процесса.
· Эозинофилы (EO)- ведущие форменные элементы в борьбе с паразитами (простейшие, гельминты), принимают участие в аллергических реакциях.
· Базофилы (BA)- принимают участие в аллергических реакциях, а также в регуляции кровообращения посредством секреции гормоноподобных веществ: гистамин, серотонин и гепарин.
· Лимфоциты (LYM)- играют центральную роль во всех иммунологических реакциях организма. Благодаря рецепторам на поверхности клеток, они способны различать "свое" и "чужое". Основная функция LYM- синтез защитных антител и обеспечение иммунной памяти.
· Моноциты (MON)- агранулоцитарные клетки, которые находятся в крови несколько суток, затем покидают кровоток перемещаясь в ткани, где выполняют свою функцию как макрофаги, фагоцитируя частицы более крупных размеров, чем нейтрофилы, а иногда и целые микробные агенты.
· Плазматические клетки (Плазмоциты)- клетки лимфоидной ткани, развивающиеся из клеток – предшественниц В-лимфоцитов, ответственные за выработку антител, в ответ на стимуляцию чужеродными антигенами. В норме в крови плазмоциты не циркулируют.
· СОЭ- определяется интенсивностью и скоростью склеивания эритроцитов в кровеносном русле. Этот параметр косвенно указывает на наличие патологического процесса, например, воспаления, в организме.
Для расшифровки анализа все перечисленные показатели важно оценивать в комплексе, а не по-одному. К тому же, для правильной интерпретации изменений в ОАК необходимо учитывать возрастные особенности лейкоцитарной формулы.

При рождении ребенка количество нейтрофилов(NE) преобладает над содержанием лимфоцитов (LYM). На 4-5 дни величина NE и LYM находится приблизительно на одном уровне (Первый перекрест). Далее, начиная со 2-го месяца жизни ребенка, число NE снова уменьшается, а LYM - возрастает, следом показатель NE нарастает, а LYM снижается. Затем, в 4 года количество клеток примерно одинаково (Второй перекрест). Наконец, к четырнадцатилетнему возрасту, процентное соотношении лейкоцитов (WBC) соответствует показателям взрослого человека.
В таблице представлены показатели процентного соотношения WBC.
Признаки бактериальной инфекции по анализу крови.
Человеческий организм постоянно сталкивается с внешними угрозами в виде патогенных микроорганизмов. При подготовке к возможному повреждению в крови быстро образуется мобильный пул циркулирующих нейтрофилов, в результате ускоренного выхода гранулоцитов из красного костного мозга, прекращения выхода нейтрофилов в ткани и мобилизацией пристеночного пула элементов.
При острых бактериальных инфекциях количество этих элементов в крови резко увеличивается, могут появляться менее зрелые клетки. (Сдвиг влево). Интенсивное разрушение зрелых нейтрофилов в тканях приводит к активной продукции костным мозгом более юных клеток. В крови увеличивается количество как самих лейкоцитов, так и отдельной фракции – нейтрофилов.
Чем выше количество этих клеток, тем более активен воспалительный процесс в организме. Нередко эти изменения помогают выявить признаки бактериальной инфекции по анализу крови у взрослых. При воспалительном процессе бактериальной этиологии, характерно повышение в плазме крови некоторых воспалительных белков (фибриногена, церулоплазмина, иммуноглобулинов). Некоторые из этих белков присоединяются к эритроцитам, следовательно, СОЭ увеличивается в разы.
Анализ крови при вирусной инфекции.
Вирусу для репликации необходима полноценная клетка организма, которую он использует как полигон для производства собственного генома, поэтому вирус находит и поражает определенные клетки, содержащие на своей поверхности специфические рецепторы. Для того, чтобы клетки иммунной системы могли отличать инфицированную клетку от здоровой и уничтожить ее, в качестве «метки зараженности» выступают белки главного комплекса гистосовместимости класса I (MHC I). Так активируются Т-лимфоциты, имеющие на своей поверхности определенные рецепторы, с помощью которых они распознают меченные, а значит инфицированные клетки.
В связи с этим, при острых вирусных заболеваниях в ОАК увеличиваться количество лимфоцитов и/или моноцитов. Общее количество лейкоцитов обычно снижено или в пределах возрастной нормы.
Однако при патологическом процессе вирусной этиологии анализ крови может соответствовать и нормальным показателям здорового человека, а при течении бактериального процесса количество лейкоцитов и абсолютное число нейтрофилов не всегда являются надежным маркером. Именно поэтому для назначения эффективного и адекватного лечения каждый случай должен оцениваться врачом индивидуально.
Кроме того, в настоящее время можно защитить себя и своих родных от многих вирусных и бактериальных инфекций с помощью эффективной и безопасной вакцинации.
Автор: врач-ординатор Университетской клиники H-Clinic Пушик Елена Павловна
Медицинский редактор: руководитель Университетской клиники, к.м.н., врач-инфекционист Коннов Данила Сергеевич
Читайте также:
